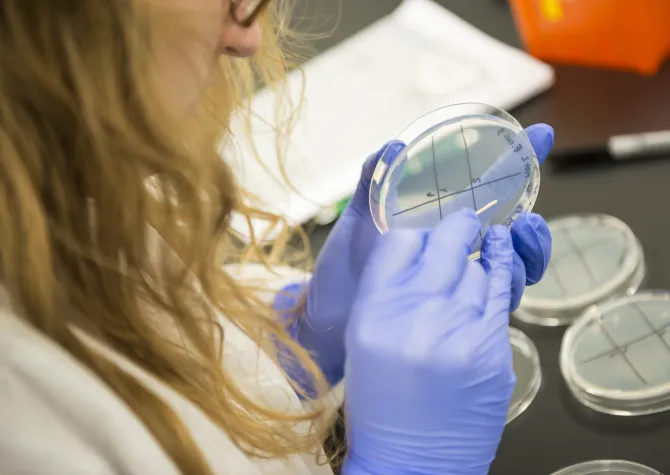
Student working in a lab wearing blue gloves and a white lab coat.

Majors
The Department of Biological Sciences offers an undergraduate major in Biology with emphases in Biomedical Science, Ecology and Conservation Science, and Environmental Science. Students may also major in Biological Sciences Education and Comprehensive Science Education.
High-Impact Programs
Learning Assistants
Learning Assistants are undergraduate students who support faculty and peers in large-enrollment courses, making classrooms more engaging and effective through small-group interaction and active participation.
Summer REU
The REU Programs at NDSU offer undergraduates an immersive summer research experience in a collaborative academic environment. Build your skills, expand your network, and contribute to cutting-edge discoveries.
Peer Mentor Program
Our Peer Mentor Program connects new students with experienced mentors who offer guidance, encouragement, and insider tips to help you thrive at NDSU, academically, socially, and personally.
ROPES
Faculty members in the College of Arts and Sciences invite you to join them in their labs and in the field. Our cutting- edge researchers are ready to show you the ropes of scientific research and give you a front-row seat for the latest discoveries in their fields.
